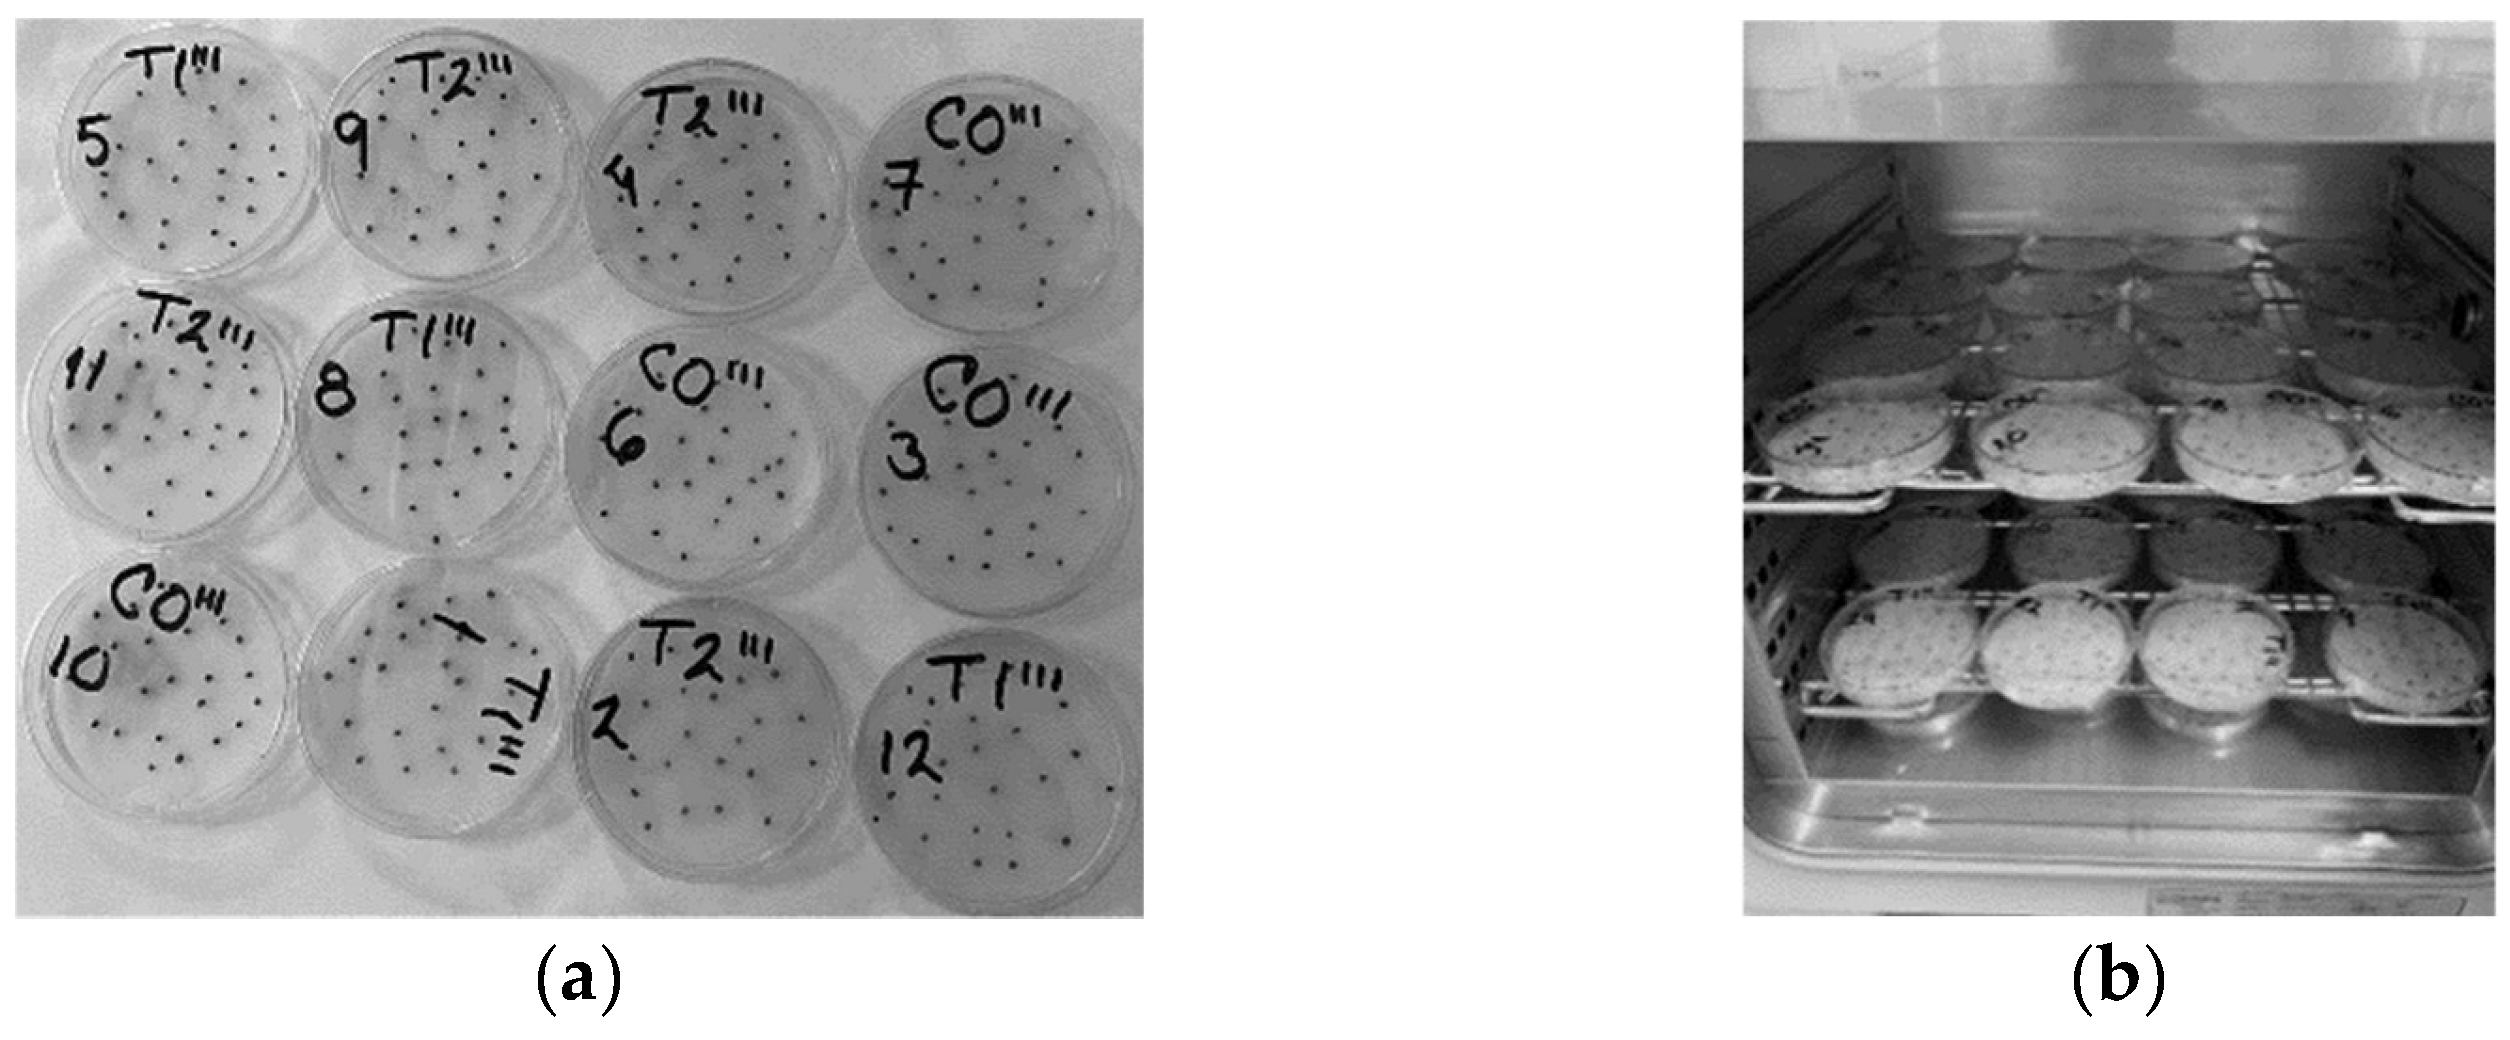
Seeds 03 00013 g002

Magneto-Priming of Seeds Decreases the Saline Effect of Wastewater Irrigation on Broccoli Germination and Seedling Growth
Abstract
1. Introduction
2. Material and Methods
3. Results
3.1. Germination Test
3.2. Growth Test
4. Discussion
5. Conclusions
- On the seventh day, the stem and root lengths of primed and non-primed seeds irrigated with distilled water were significantly higher than those of seeds irrigated with wastewater. Roots of primed and non-primed seeds irrigated with distilled water were longer than those of seeds irrigated with wastewater, but only significant differences were obtained for primed seeds. Significant differences were found in total fresh weight of primed and non-primed seeds irrigated with distilled water in comparison to the seeds irrigated with wastewater;
- On the tenth day, the stem and root lengths of both primed and non-primed seeds were longer when irrigated with distilled water than with wastewater, but only significant differences were observed in the first case, and identical behaviour was observed on total fresh weight. The growth parameters of non-primed seeds were lower than those obtained for primed seeds when irrigated with distilled water, but non-significant differences were obtained for most parameters. In addition, all the growth parameters of magneto-primed seeds were higher than those obtained for non-primed seeds when irrigated with wastewater, although only significant differences were obtained for root length;
- Broccoli seedings irrigated with distilled water grew higher and heavier than the ones irrigated with wastewater, probably due to the significant amounts of salts in organic wastewater. Nonetheless, the magneto-priming of seeds decreases the saline effect of wastewater irrigation on broccoli plant growth;
- All the germination parameters were enhanced when seeds were irrigated with wastewater and magnetically treated; in comparison with those that had not been treated, the most significant differences were observed in seeds that were magneto-primed for 2 h;
- The onset of the germination, characterized by the t10 parameter, was reduced by 6 h versus the control when seeds were magneto-primed for 2 h;
- The percentage of germinated seeds irrigated with wastewater was 85 ± 3 h, while the magneto-primed seeds achieved 91 and 95%, respectively.
Author Contributions
Funding
Institutional Review Board Statement
Informed Consent Statement
Data Availability Statement
Conflicts of Interest
References
- Mateo-Sagasta, J.; Zadeh, S.M.; Turral, H.; Burke, J. Water Pollution from Agriculture: A Global Review. Executive Summary; FAO: Rome, Italy, 2017. [Google Scholar]
- Pescod, M.B. Wastewater Treatment and Use in Agriculture-FAO Irrigation and Drainage Paper 47; FAO: Rome, Italy, 1992. [Google Scholar]
- Al-Nakshabandi, G.A.; Saqqar, M.M.; Shatanawi, M.R.; Fayyad, M.; Al-Horani, H. Some environmental problems associated with the use of treated wastewater for irrigation in Jordan. Agric. Water Manag. 1997, 34, 81–94. [Google Scholar] [CrossRef]
- Tabatabaei, S.; Nourmahnad, N.; Golestani Kermani, S.; Tabatabaei, S.; Najafi, P.; Heidarpour, M. Urban wastewater reuse in agriculture for irrigation in arid and semi-arid regions—A review. Int. J. Recycl. Org. Waste Agric. 2020, 9, 193–220. [Google Scholar] [CrossRef]
- Angelakis, A.N.; Koutsoyiannis, D.; Tchobanoglous, G. Urban wastewater and stormwater technologies in ancient Greece. Water Res. 2005, 39, 210–220. [Google Scholar] [CrossRef] [PubMed]
- Asano, T.; Levine, A.D. Wastewater reclamation, recycling and reuse: Past, present, and future. Water Sci. Technol. 1996, 33, 1–14. [Google Scholar] [CrossRef]
- Bichai, F.; Polo-López, M.I.; Ibáñez, P.F. Solar disinfection of wastewater to reduce contamination of lettuce crops by Escherichia coli in reclaimed water irrigation. Water Res. 2012, 46, 6040–6050. [Google Scholar] [CrossRef]
- Fendri, I.; Ben Saad, R.; Khemakhem, B.; Ben Halima, N.; Gdoura, R.; Abdelkafi, S. Effect of treated and untreated domestic wastewater on seed germination, seedling growth and amylase and lipase activities in Avena sativa L. J. Sci. Food Agric. 2013, 93, 1568–1574. [Google Scholar] [CrossRef]
- Osburn, R.M.; Schroth, M.N. Effect of osmopriming sugar beet seed on germination rate and incidence of Pythium ultimum damping-off. Plant Dis. 1989, 73, 21–24. [Google Scholar] [CrossRef]
- Nonogaki, H.; Bassel, G.W.; Bewley, J.D. Germination-still a mystery. Plant Sci. 2010, 179, 574–581. [Google Scholar] [CrossRef]
- Ranal, M.A.; De Santana, D.G. How and why to measure the germination process? Rev. Bras. Bot. 2006, 29, 1–11. [Google Scholar] [CrossRef]
- Paparella, S.; Araújo, S.S.; Rossi, G.; Wijayasinghe, M.; Carbonera, D.; Balestrazzi, A. Seed priming: State of the art and new perspectives. Plant Cell Rep. 2015, 34, 1281–1293. [Google Scholar] [CrossRef]
- ISTA (International Seed Testing Association). International Rules for Seed Testing; ISTA Editions: Zurich, Switzerland, 2004. [Google Scholar]
- Black, M.; Bewley, J.D. Seed Technology and Its Biological Basis; Sheffield Academic Press: Sheffield, UK, 2000. [Google Scholar]
- Nascimento, W.M.; De Aragão, F.A.S. Muskmelon seed priming in relation to seed vigor. Sci. Agric. 2004, 61, 114–117. [Google Scholar] [CrossRef]
- Evenari, M. Seed physiology: Its history from antiquity to the beginning of the 20th century. Bot. Rev. 1984, 50, 119–142. [Google Scholar] [CrossRef]
- Dursun, A.; Ekinci, M. Effects of different priming treatments and priming durations on germination percentage of parsley (Petroselinum crispum L.) seeds. Agric. Sci. 2010, 1, 17. [Google Scholar] [CrossRef]
- Raj, A.B.; Raj, S.K. Seed priming: An approach towards agricultural sustainability. J. Appl. Nat. Sci. 2019, 11, 227–234. [Google Scholar] [CrossRef]
- Pietruszewski, S.; Martínez, E. Magnetic field as a method of improving the quality of sowing material: A review. Int. Agrophys. 2015, 29, 377–389. [Google Scholar] [CrossRef]
- Martínez, E.; Flórez, M.; Carbonell, M.V. Stimulatory effect of magnetic treatment on the germination of cereal seeds. Int. J. Environ. Agric. Biotechnol. 2017, 2, 375–381. [Google Scholar] [CrossRef]
- Flórez, M.; Carbonell, M.V.; Martínez, E.; Alvarez, J. Stimulatory effect of magnetic treatment prior to sowing on the germination and initial growth of triticale seeds. Int. J. Environ. Agric. Biotechnol. 2016, 1, 125–131. [Google Scholar]
- Alvarez, J.; Martínez, E.; Carbonell, M.V.; Flórez, M. Magnetic time model for triticale seed germination. Rom. J. Phys. 2019, 64, 822. [Google Scholar]
- Alvarez, J.; Carbonell, M.V.; Martínez, E.; Flórez, M. The use of Peleg’s equation to model water absorption in Triticale (X Triticosecale Wittmack) seeds magnetically treated before soaking. Rom. J. Phys. 2019, 64, 80. [Google Scholar]
- Alvarez, J.; Martínez, E.; Carbonell, M.V.; Flórez, M. Effects of Polyethylene glycol and Sodium Chloride stress on water bastion of magneto-primed Triticale seeds. Rom. J. Phys. 2020, 72, 708. [Google Scholar]
- Lu, Y.; Song, S.; Wang, R.; Liu, Z.; Meng, J.; Sweetman, A.J.; Jenkins, A.; Ferrier, R.C.; Li, H.; Luo, W. Impacts of soil and water pollution on food safety and health risks in China. Environ. Int. 2015, 77, 5–15. [Google Scholar] [CrossRef]
- McCauley, A.; Jones, C.; Jacobsen, J. Plant nutrient functions and deficiency and toxicity symptoms. Nutr. Manag. Modul. 2009, 9, 1–16, US, Montana State University. [Google Scholar]
- Shafi, M.; Bakht, J.; Hassan, M.J.; Raziuddin, M.; Zhang, G. Effect of cadmium and salinity stresses on growth and antioxidant enzyme activities of wheat (Triticum aestivum L.). Bull. Environ. Contam. Toxicol. 2009, 82, 772–776. [Google Scholar] [CrossRef]
- Kataria, S.; Baghel, L.; Guruprasad, K.N. Pre-treatment of seeds with static magnetic field improves germination and early growth characteristics under salt stress in maize and soybean. Biocatal. Agric. Biotechnol. 2017, 10, 83–90. [Google Scholar] [CrossRef]
- Pittman, U.J. Magnetism and plant growth: I. Effect on germination and early growth of cereal seeds. Can. J. Plant Sci. 1963, 43, 513–518. [Google Scholar] [CrossRef]
- Pittman, U.J. Magnetism and plant growth: III. Effect on germination and early growth of corn and beans. Can. J. Plant Sci. 1965, 45, 549–555. [Google Scholar] [CrossRef]
- Pittman, U.J.; Anstey, T.H. Magnetic treatment of seed orientation of a single harvest snap bean (Phaseolus vulgaris L.). Proc. Am. Soc. Hortic. Sci. 1967, 91, 310–314. [Google Scholar]
- Vakharia, D.N.; Davariya, R.L.; Parameswaran, M. Influence of magnetic treatment on groundnut yield and yield attributes. Indian J. Plant Physiol. 1991, 24, 131–136. [Google Scholar]
- Vashisth, A.; Nagarajan, S. Exposure of seeds to static magnetic field enhances germination and early growth characteristics in chickpea (Cicer arietinum L.). Bioelectromagnetics 2008, 29, 571–578. [Google Scholar] [CrossRef] [PubMed]
- Vashisth, A.; Nagarajan, S. Effect on germination and early growth characteristics in sunflower (Helianthus annuus) seeds exposed to static magnetic field. J. Plant Physiol. 2010, 167, 149–156. [Google Scholar] [CrossRef] [PubMed]
- Zhao, Y.; Zhuang, X.; Ahmad, S.; Sung, S.; Ni, S. Biotreatment of high-salinity wastewater: Current methods and future directions. World J. Microbiol. Biotechnol. 2020, 36, 37. [Google Scholar] [CrossRef] [PubMed]
- Cai, W.; Chen, Q.; Zhang, J.; Li, Y.; Xie, W.; Wang, J. Effects of High Salinity on Alginate Fouling during Ultrafiltration of High-Salinity Organic Synthetic Wastewater. Membranes 2021, 11, 590. [Google Scholar] [CrossRef]
- Meiri, A.; Poljakoff-Mayber, A. Effect of various salinity regimes on growth, leaf expansion and transpiration rate of bean plants. Soil Sci. 1970, 109, 26–34. [Google Scholar] [CrossRef]
- Ghiyasi, M.; Seyahjani, A.A.; Tajbakhsh, M.; Amirnia, R.; Salehzadeh, H. Effect of osmopriming with polyethylene glycol (8000) on germination and seedling growth of wheat (Triticum aestivum L.) seeds under salt stress. Res. J. Biol. Sci. 2008, 3, 1249–1251. [Google Scholar]

| Exposure Time | Label |
|---|---|
| 0 | CO/CO‴ |
| 2 h | T1/T1‴ |
| 1 h | T2/T2‴ |
| Label | t10 (h) | t50 (h) | t75 (h) | MGT (h) | Gmax (%) |
|---|---|---|---|---|---|
| C0‴ | 26.5 ± 0.3 b | 38.7 ± 2.0 b | 64.2 ± 0.9 b | 39.2 ± 1.2 b | 85 ± 3 a |
| T1‴ | 20.5 ± 1.6 a | 32.8 ± 1.3 a | 49.7 ± 4.2 a | 34.2 ± 1.2 a | 91 ± 4 ab |
| T2‴ | 23.2 ± 2.3 ab | 36.0 ± 2.5 ab | 47.9 ± 3.7 ab | 37.2 ± 2.4 ab | 95 ± 3 b |
| Water | Label | Stem Length (cm) p < 0.01 | Root Length (cm) p < 0.01 | Fresh Weight (mg) p < 0.01 |
|---|---|---|---|---|
| Distilled water | D-C | 4.50 ± 0.15 b | 2.66 ± 0.19 ab | 53.20 ± 1.98 b |
| D-P | 5.65 ± 0.15 c | 4.21 ± 0.18 c | 76.93 ± 1.97 c | |
| Wastewater | W-C | 3.47 ± 0.15 a | 1.92 ± 0.18 a | 43.66 ± 1.96 a |
| W-P | 4.05 ± 0.14 ab | 3.03 ± 0.16 b | 50.04 ± 2.00 ab |
| Water | Label | Stem Length (cm) p < 0.01 | Root Length (cm) p < 0.01 | Fresh Weight (mg) p < 0.01 |
|---|---|---|---|---|
| Distilled water | D-C | 8.55 ± 0.21 b | 3.64 ± 0.20 b | 73.18 ± 2.36 b |
| D-P | 7.62 ± 0.19 a | 3.00 ± 0.16 b | 69.16 ± 2.02 ab | |
| Wastewater | W-C | 7.00 ± 0.21 a | 2.09 ± 0.19 a | 62.09 ± 2.21 a |
| W-P | 7.40 ± 0.21 a | 3.18 ± 0.18 b | 66.32 ± 2.18 ab |
Disclaimer/Publisher’s Note: The statements, opinions and data contained in all publications are solely those of the individual author(s) and contributor(s) and not of MDPI and/or the editor(s). MDPI and/or the editor(s) disclaim responsibility for any injury to people or property resulting from any ideas, methods, instructions or products referred to in the content. |
© 2024 by the authors. Licensee MDPI, Basel, Switzerland. This article is an open access article distributed under the terms and conditions of the Creative Commons Attribution (CC BY) license (https://creativecommons.org/licenses/by/4.0/).
Share and Cite
Gutierrez, J.; Alonso, F.; Alvarez, J.; Carbonell, M.V.; Martinez, E.; Florez, M.; Delgado, M.d.M.; Franco, B.K.; Hernandez-Aguilar, C. Magneto-Priming of Seeds Decreases the Saline Effect of Wastewater Irrigation on Broccoli Germination and Seedling Growth. Seeds 2024, 3, 169-178. https://doi.org/10.3390/seeds3010013
Gutierrez J, Alonso F, Alvarez J, Carbonell MV, Martinez E, Florez M, Delgado MdM, Franco BK, Hernandez-Aguilar C. Magneto-Priming of Seeds Decreases the Saline Effect of Wastewater Irrigation on Broccoli Germination and Seedling Growth. Seeds. 2024; 3(1):169-178. https://doi.org/10.3390/seeds3010013
Chicago/Turabian StyleGutierrez, Julio, Francisco Alonso, Jose Alvarez, María Victoria Carbonell, Elvira Martinez, Mercedes Florez, María del Mar Delgado, Brenda Katherine Franco, and Claudia Hernandez-Aguilar. 2024. "Magneto-Priming of Seeds Decreases the Saline Effect of Wastewater Irrigation on Broccoli Germination and Seedling Growth" Seeds 3, no. 1: 169-178. https://doi.org/10.3390/seeds3010013
APA StyleGutierrez, J., Alonso, F., Alvarez, J., Carbonell, M. V., Martinez, E., Florez, M., Delgado, M. d. M., Franco, B. K., & Hernandez-Aguilar, C. (2024). Magneto-Priming of Seeds Decreases the Saline Effect of Wastewater Irrigation on Broccoli Germination and Seedling Growth. Seeds, 3(1), 169-178. https://doi.org/10.3390/seeds3010013

